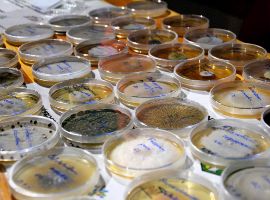
231006_Noc vedcu_K.Capounova (178)

Co všechno „vidí“ dron na poli? K čemu slouží sedlákům satelity a lidstvu genové banky? O chytrém zemědělství, rostlinách, které léčí rostliny, potravinářském i nepotravinářském využívání hub, molekulární genetice i dopadech, které mají invazní škůdci na naši přírodu. To, a ještě více se dozvíte na interaktivním stanovišti Národního centra zemědělského a potravinářského výzkumu, v. v. i., které je největší českou výzkumnou institucí zaměřenou na udržitelný rozvoj zemědělství a potravinářství a významnou vědeckou institucí v oblasti aplikovaného výzkumu v České republice. Připraveny jsou poznávačky, skládačky, pipetování i virtuální řízení dronu pro malé i velké.
Biosmršť a Týden invazních druhů. Jste duší badatelé a baví vás příroda? Staňte se občanským výzkumníkem a pomozte mapovat výskyt nepůvodních druhů v naší přírodě.
Pokladnice jménem genová banka. Genové banky hrají klíčovou roli v ochraně rozmanitosti života. Co se stane, když na planetě zanikne plodina nebo mikroorganismus. Jak se pro budoucí generace uchovávají odrůdy zemědělských plodin či mikroorganizmy pro výrobu piv, vín či sýrů. Vyzkoušej si práci molekulárních biologů! Pomocí DNA odhalujeme původ rostlin i přítomnost chorob. Přijď si pipetovat, skládat proteiny nebo kreslit na agar a objevit svět skrytý v rostlinných buňkách.
Precizní technologie mění zemědělství. Díky nim dokážeme (nejen) na polích snáze sledovat a analyzovat různé jevy i snižovat užívání pesticidů. Seznamte se se zobrazovací a senzorovou technikou a bezpilotními prostředky. Vyzkoušejte si ve virtuálním režimu, jak fungují. Existuje alternativa syntetických prostředků na ochranu rostlin? Představíme vám, co jsou a jak fungují botanické preparáty a predátorský užitečný hmyz při ochraně úrody.